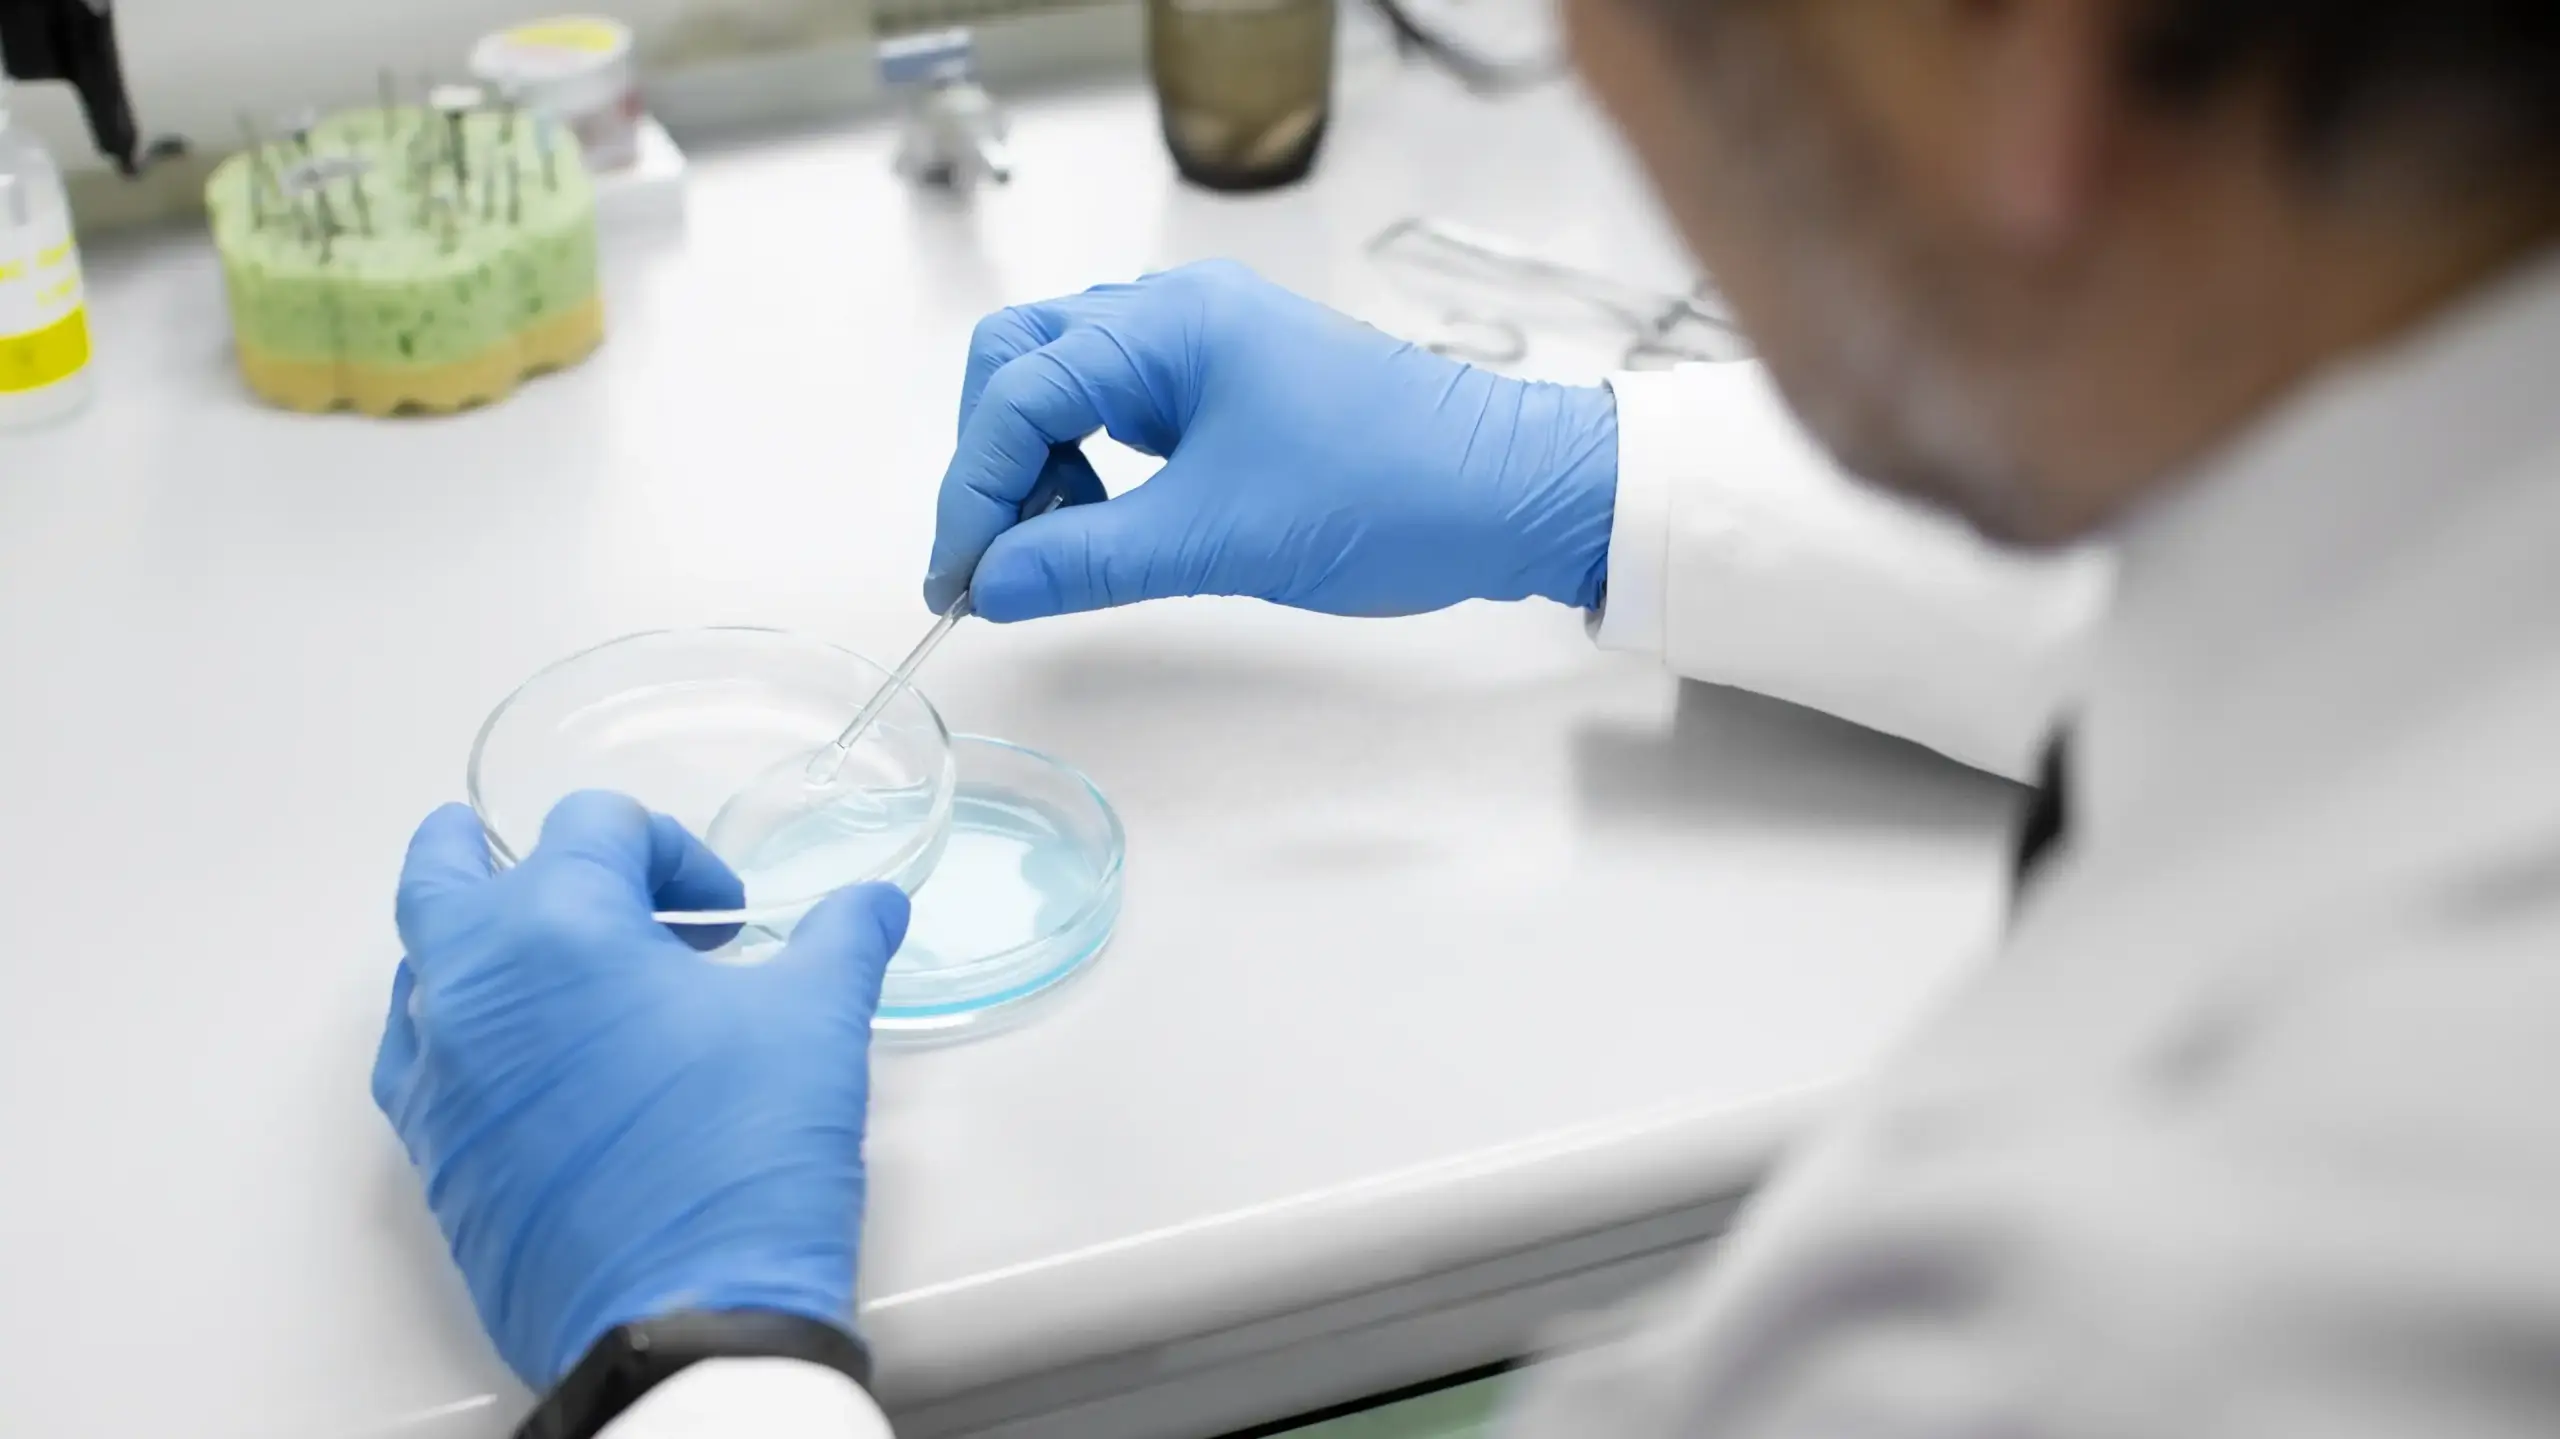

Yerli ve Güvenilir Fason Kozmetik Üretim
Marka Sizden üretim Bizden!
Kozmetik sektörüne adım atmak isteyen genç girişimciler ve mevcut markasını büyütmek isteyen firmalar için özel üretim hizmeti sunuyoruz. Uygun minimum adet, modern üretim tesisleri ve uzman ekibimizle markanıza değer katıyoruz.



Talebiniz bize ulaşmıştır. Uzman ekip arkadaşımız kısa vakit içerisinde geri dönüş sağlayacaktır.
10+
Yıllık Tecrübe ile Güvenilir Çözümler
100%
Müşteri memnuniyeti
Pazartesi – Cumartesi: 08:00-18:00
Hayalinizdeki kozmetik ürünleri biz üretelim, siz markalaştırın!
Geniş ürün yelpazemizle; ağız bakımından cilt bakımına, parfümden kolonyaya kadar ihtiyaç duyduğunuz tüm kozmetik ürünlerini hijyenik ve kaliteli üretimle sizin için hazırlıyoruz.

Serumlar
Cildinize ihtiyacı olan yoğun bakımı sunan yenileyici ve nemlendirici serum çeşitleri.

Kremler
El, yüz ve vücut için özel formüle edilmiş nemlendirici ve onarıcı kremler.

Yüz Bakım
Yüzünüz için özel formüllerle hazırlanmış temizleme, nemlendirme ve bakım ürünleri.

Ağız Bakım
Doğal içerikli diş macunları ve ağız bakım ürünleriyle sağlıklı gülüşlere kavuşun.

Parfümler
Kalıcı ve etkileyici kokularla markanızı farklı kılacak özgün parfüm üretimleri.

Kolonya
Hem hijyen hem ferahlık sağlayan kaliteli ve farklı esans seçenekleriyle kolonya.

Sabunlar
Doğal özlerle üretilmiş katı ve sıvı sabun çeşitleriyle temizlik ve bakım bir arada.

Vücut Bakım
Cildinizi besleyen, nemlendiren ve pürüzsüz bir dokunuş sunan vücut bakım ürünleri.
Ne sunuyoruz!
İhtiyaçlarınıza
Özel Çözümler
Genç girişimcilerden kurumsal markalara kadar, kozmetik üretim sürecinin her aşamasında yanınızdayız: Ürün fikrinden formül geliştirmeye, ambalaj ve etiket tasarımından sertifikasyon, barkod ve mevzuat süreçlerine kadar uçtan uca destek sunuyoruz. Düşük minimum adetlerle esnek üretim, hızlı numune ve ölçeklenebilir çözümlerle markanızı güvenle büyütün.

1- Ürün Belirleme
Markan için doğru ürün veya ürün gamını seçerek sürecin ilk adımını başlatıyoruz.

2- Fason Sözleşmesi
Karşılıklı anlaşma sonrası süreci güvence altına alan fason sözleşmesini tamamlıyoruz.

3- Marka Başvurusu
Türk Patent süreçlerinde marka tescil başvurusu için girişimcilere profesyonel destek veriyoruz.

4- Ar-Ge & Numune
Size özel formül geliştiriyor, numune ürün hazırlayarak onayınıza sunuyoruz.

5- Ambalaj Seçimi
Ürününüzü öne çıkaracak ambalajı birlikte seçiyor, marka değerini güçlendiriyoruz.

6- Barkod Hizmeti
Ürünün kimliği olan barkod numarasını temin ederek piyasada yer almasını sağlıyoruz.

7- Etiket Tasarımı
Ambalajınıza uygun, dikkat çekici ve yasalara uygun etiket tasarımı hazırlıyoruz.

8- Sertifikasyon Başvuruları
Vegan, helal, organik vb. sertifikalar için başvuru ve belgelendirme sürecini yönetiyoruz.

9- Mesul Müdür Ataması
Zorunlu hallerde mesul müdür atamasında girişimcilere destek sağlıyoruz.
10- Laboratuvar Analizleri
Ürün güvenliği için Sağlık Bakanlığı onaylı laboratuvarlarda gerekli testleri yaptırıyoruz.

11- GBF Dosyaları
Ürünleriniz için gerekli GBF dosyalarını uzman desteği ile hazırlıyoruz.

12- ÜTS Girişleri
Ürününüzü Sağlık Bakanlığı ÜTS sistemine kaydediyor, tüm bildirimleri tamamlıyoruz.

13- Piyasaya Hazır Teslim
Tüm aşamaları tamamlanan ürününüzü satışa hazır şekilde girişimcinize teslim ediyoruz.

Fason Kozmetik Üretim
Yimsa Kimya olarak fason kozmetik üretim hizmetlerimiz kapsamında geniş ürün yelpazesi sunuyoruz. Cilt bakım ürünlerinden vücut ve yüz bakımına, ağız bakımından güneş ürünlerine, parfüm ve kolonyalardan ev bakım ve temizlik ürünlerine kadar birçok kategoride profesyonel üretim desteği sağlıyoruz. Kataloğumuzu indirerek ürettiğimiz ürün çeşitlerini detaylı inceleyebilir, markanız için en uygun ürünleri seçerek kendi kozmetik markanızı güvenle oluşturabilirsiniz.
Yimsa Kimya Hakkında
Güvenilir, Yenilikçi ve Tecrübeli Fason Üretim
Yimsa Kimya, 10+ yıllık tecrübesiyle girişimcilere ve markalara güvenilir fason kozmetik üretimi sunar. Ürün seçimi, Ar-Ge, üretim, ambalaj, sertifikasyon ve teslimat süreçlerinde tam destek sağlayarak kaliteli ve profesyonel çözümler üretir.
10+ Yıllık Tecrübe
Tüm Süreçte Destek
Yerli Üretim & Sertifikalı
Hızlı & Esnek Üretim
Güvenle Yatırım Yapın, Karlılığınızı Artırın
Her Adımda Yanınızda, Profesyonel Destekle Üretim
Yimsa Kimya, girişimcilere ve markalara uygun maliyetli fason kozmetik üretimi fırsatları sunar. Profesyonel ekibimiz, ürün seçimi, Ar-Ge, üretim, ambalaj, sertifikasyon ve teslimat süreçlerinde yanınızda olarak tüm adımları güvenle yönetir. Yatırımınızı verimli kullanmanızı sağlayarak kârlı üretim ve marka büyümesini destekler. Sadece üretim değil, stratejik bir iş ortağı olarak markanızın her aşamasında yanınızdayız.
Modern profesyonel yaklaşım
Uygun Fiyatla Karlı Üretim
100%
Müşteri Memnuniyeti
Ürünlerimiz hakkında bilgi alın, ihtiyaçlarınıza uygun çözümleri hızlıca keşfedin.
Hızlı Numune Talebi
Uzman Destek
İhtiyacınıza Özel Üretim